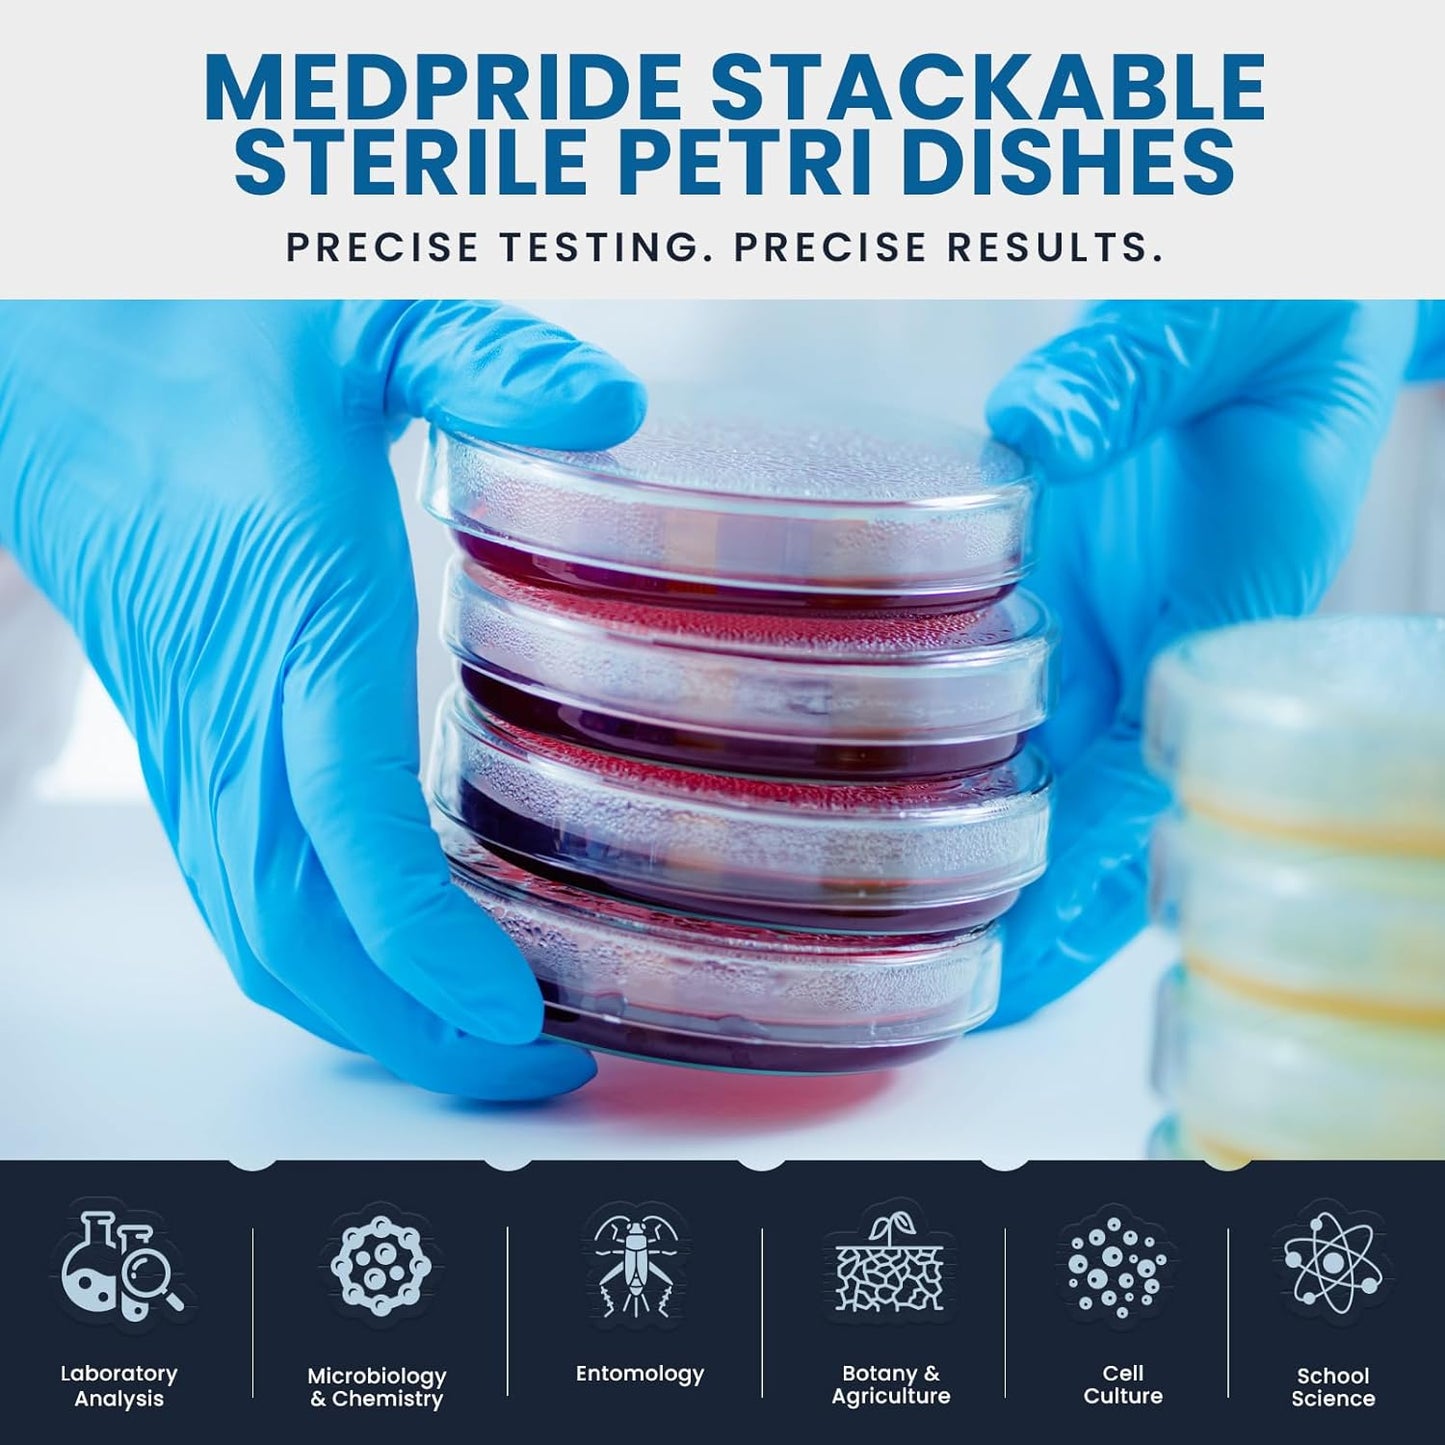
MedPride Stackable Petri Dishes with Lids, Sterile 90mmx15mm -  20 Pack of 25 (500 Count)

MedPride Stackable Petri Dishes with Lids, Sterile 90mmx15mm - 20 Pack of 25 (500 Count)
MedPride Stackable Petri Dishes with Lids, Sterile 90mmx15mm - 20 Pack of 25 (500 Count) is backordered and will ship as soon as it is back in stock.

MedPride Stackable Petri Dishes with Lids, Sterile 90mmx15mm - 20 Pack of 25 (500 Count) is backordered and will ship as soon as it is back in stock.
Description
Description
MedPride Stackable Petri Dishes with Lids, Sterile are perfect for a wide range of laboratory applications, from biology and science experiments to blood tests and cell culture work.
These sterile, 90mm x 15mm dishes come with secure, easy-to-use lids to prevent contamination and ensure sample integrity. The stackable design makes them convenient for storage and handling, while the clear plastic allows for easy visibility of specimens under a microscope.
Whether you're conducting experiments, performing research, or analyzing biological samples, these high-quality Petri dishes offer reliability and precision. Ideal for labs, educational settings, and medical facilities, MedPride Stackable Petri Dishes with Lids, Sterile are a must-have for scientific and clinical applications.
- 500 dishes (20 packs x 25 dishes).
Payment & Security
Payment methods
Your payment information is processed securely. We do not store credit card details nor have access to your credit card information.